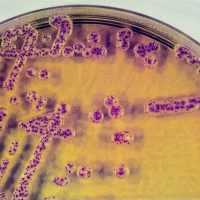
Дисбиоз кишечника

УЗИ желчного пузыря при холестериновом полипе
Добавил пользователь Владимир З. Обновлено: 09.01.2026
Полип желчного пузыря - это избыточное разрастание тканей слизистой оболочки желчного пузыря.
Распространенность
Частота выявления полипа(ов) желчного пузыря (ПЖП): при ультразвуковом исследовании органа - 0,3-9,5%; после операции (удаление желчного пузыря, холецистэктомия) - 0,05-13,8%.
Классификация
Выделяют псевдополипы и истинные полипы желчного пузыря. Согласно современным представлениям при проведении ультразвукового исследования (УЗИ) в 70-90% случаев полиповидные образования желчного пузыря оказываются псевдополипами. Псевдополипы всегда доброкачественные, т.е. не способны к перерождению в рак. Они могут быть воспалительного происхождения (5-10% всех полипов) или связаны с нарушением состава желчи (70-90%).
Истинные полипы желчного пузыря могут быть доброкачественными (аденома) или злокачественным (аденокарцинома желчного пузыря или рак желчного пузыря). Существуют данные о том, что со временем часть аденом может трансформироваться в аденокарциному.

Распространенность аденокарциномы желчного пузыря варьирует в зависимости от групп риска. Так, среди лиц с высоким риском развития этого заболевания (например, жители Северной Индии) рак желчного пузыря встречается у 27 человек из 100 тыс. населения. У лиц из группы низкого риска аденокарцинома желчного пузыря встречается с частотой 1,5/100 тыс. населения. Важным представляется своевременное выявление рака желчного пузыря: при обнаружении его на первой стадии 5-летняя выживаемость стремится к 100%, на второй - 57-72%.
Симптомы
Сами по себе ПЖП не вызывают появления симптомов, однако различные жалобы могут наблюдаться при сочетанной патологии желчного пузыря (желчнокаменная болезнь, билиарная дисфункция и т.д.).
Диагностика
Своевременная диагностика является очень важным этапом, на котором оценивается характер полипа и решается вопрос о его доброкачественности/ злокачественности.
УЗИ желчного пузыря. Оценка желчного пузыря ультразвуковым методом обычно проводится в рамках УЗИ органов брюшной полости. В этом случае ПЖП виден как выпячивание в просвет органа, неподвижное, без эхо-тени. Полип может быть плоским или «на ножке». Нередко при проведении УЗИ выявляются признаки псевдополипа, чаще всего т.н. «холестериновый полип».
УЗИ органов брюшной полости является основным методом рутинной диагностики ПЖП.
Дополнительные методы включают УЗИ желчного пузыря с контрастированием, компьютерную томографию, эндосонографию.
Онкомаркеры не позволяют достоверно разделить группу пациентов с доброкачественными и злокачественными полипами.
Тактика ведения пациентов
Тактика ведения пациентов с истинными полипами желчного пузыря
Задача врача, к которому обратился пациент с ПЖП, сделать правильный выбор: оценить риск трансформации доброкачественного полипа в злокачественную опухоль и своевременно принять решение по лечению.
В этом помогают рекомендации, основанные на клинических исследованиях. Так, в 2017 году вышли Европейские рекомендации по лечению и наблюдению за ПЖП, подготовленные совместно гастроэнтерологами, хирургами, специалистами лучевой и эндоскопической диагностики.
Тактика в отношении ПЖП (наблюдать или лечить) определяется рядом факторов:
- размер полипа;
- факторы риска озлокачествления (малигнизации);
- динамика роста;
- наличие симптомов со стороны желчного пузыря.
Размеры полипа
- 10 мм и более - высокий риск малигнизации. Пациенту рекомендуется удаление желчного пузыря (холецистэктомия) при его согласии и отсутствии противопоказаний;
- менее 10 мм:
- пациенту без симптомов показано выполнение контрольного УЗИ исследования. Частота диагностики варьирует 1 раз в 6-12-24 месяцев в зависимости от размера полипа.
- пациенту с симптомами (чаще всего болью), обусловленными нарушением функции желчного пузыря, может быть предложена операция (холецистэктомия). Если имеются другие объяснения симптомов, пациент не согласен с операцией или имеются противопоказания для ее проведения, рекомендуется УЗИ-наблюдение в динамике.
Факторы риска малигнизации
- возраст старше 50 лет;
- индийская национальность;
- полип без ножки, или плоский полип (в т.ч. локальное утолщение стенки желчного пузыря ≥4 мм);
- первичный склерозирующий холангит.
При наличии факторов риска тактика ведения следующая:
- пациенту с полипом менее 6 мм рекомендуется УЗИ-контроль 1 раз в 6-12 месяцев;
- пациенту с полипами 6-9 мм рекомендуется холецистэктомия (удаление желчного пузыря) при согласии пациента и отсутствии факторов риска. Повышен риск малигнизации полипа.
Рост полипа
Рост ПЖП наблюдается редко, около 93% полипов сохраняют свои прежние размеры в ходе динамического наблюдения.
Если в процессе наблюдения полип вырос на 2 мм и более или достиг размеров 10 мм и более - рекомендуется операция (холецистэктомия) при согласии пациента и отсутствии противопоказаний.
Если при очередном исследовании квалифицированным УЗ-специалистом полип не визуализируется - рекомендуется прекратить наблюдение.
Количество ПЖП мало влияет на тактику лечения. По данным одного из исследований, при сравнении одиночных и множественных полипов размерами менее 10 мм разница в частоте выявления злокачественного роста составила всего 4,3% (чаще в единичных полипах). В полипах размерами более 10 мм одиночные полипы достоверно чаще имеют признаки злокачественного роста по сравнению с множественными ПЖП. Таким образом, наличие нескольких полипов не повышают риск малигнизации. Тактика ведения в их отношении не отличается от описанной выше для одиночного полипа.
При сочетании ПЖП с желчнокаменной болезнью тактика ведения остается прежней. Ведущими являются размер полипа и наличие симптомов со стороны желчного пузыря.
Тактика ведения пациентов с псевдополипами желчного пузыря
Холестериновые полипы - наиболее часто встречающиеся псевдополипы желчного пузыря. Их образование связано с нарушением состава (реологии) желчи, при этом в желчи меняется соотношение холестерина, желчных кислот, пигментных кристаллов и солей кальция.
Предлагается следующая тактика ведения:
- динамическое наблюдение (размер псевдополипа менее 5 мм) или
- медикаментозное лечение с назначением курсовой терапии препаратов желчных кислот (урсодеоксихолевой кислоты). Дополнительно могут использоваться регуляторы моторики, минеральные воды, диетотерапия.
Прогноз полипов желчного пузыря
Прогноз псевдополипов обычно хороший, поскольку перерождения в злокачественные формы не происходит. Истинные доброкачественные полипы желчного пузыря при правильной оценке размеров, факторов риска и соблюдении графика динамического наблюдения также обычно имеют благоприятный прогноз. Своевременная операция, выполненная по поводу злокачественного полипа желчного пузыря, показывают очень высокую 5-летнюю выживаемость с хорошим прогнозом.
Полипы желчного пузыря
Нередко на прием приходят пациенты с заключением УЗИ желчного пузыря и в беспокойстве о том, что обнаружены полипы желчного пузыря, и вопросом, что дальше делать. Хирурги предлагают оперативное лечение. Так оперировать или нет?
Под полипами желчного пузыря понимают доброкачественные опухоли, выступающие в просвет полого органа. В отличие от полипов желудка и кишечника, полипы желчного пузыря недоступны эндоскопическим методам исследования, а их гистологическое исследование возможно только в послеоперационном материале.
Виды полипов
Полипозные образования желчного пузыря бывают следующие:
- Холестериновые полипы, доброкачественные по своей природе.
- Холестероз желчного пузыря, полипозная форма.
- Истинные полипы желчного пузыря (аденомы).
- Злокачественные полипы.
Холестериновые полипы
По результатам исследований от 45 до 70 % всех полипов желчного пузыря имеют холестериновую природу, и не требуют хирургического вмешательства. По данным различных исследователей среди пациентов, подвергшихся удалению желчного пузыря (холецистоэктомии) от 39 до 63 % имели холестериновые полипы. Выявляемые полипы 4 — 10 мм в диаметре это холестериновые доброкачественные полипы, неподвижные, с ровным контуром, на широком основании, не дающие эхо-тень при ультразвуковом исследовании, чаще одиночные или множественные, не имеющие кровоснабжения.
Холестероз желчного пузыря

Это самая частая морфологическая форма полиповидных образований желчного пузыря и наблюдается от 42 -99% случаев. Ранее холестероз наблюдали редко, но с появлением УЗИ исследования это патология желчного пузыря стала выявляться очень часто.
Холестероз это доброкачественное, не воспалительного характера, заболевание, при котором наблюдаются множественные полиповидные образования в стенке желчного пузыря. Холестероз полиповидный характеризуется малыми размерами (менее 10-15 мм) и медленным ростом.
Холестериновые полипы желчного пузыря, холестероз - накопление чистого холестерина и его эфиров и желчных кислот в подслизистом слое стенки желчного пузыря в виде выростов (полипов).

Причинами таких полипов могут быть:
- общие нарушения липидного обмена,
- нарушение сократительной функции желчного пузыря — застой концентрированной желчи в нем,
- изменение состава желчи (дисхолия), вырабатываемой печенью,
- нарушение лимфообращения в стенках желчного пузыря при воспалении его.
Полипы холестериновые и холестероз желчного пузыря не являются предраковыми заболеваниями. Случаев перехода в злокачественное перерождение полиповидного холестероза не описано.
Частота полипов желчного пузыря у мужчин и женщин практически одинакова, но у мужчин чаще встречается полиповидный холестероз, а у женщин чаще холестериновые полипы и аденомы.
Полипы желчного пузыря чаще протекают бессимптомно (по результатам исследований до 66%).
Истинные полипы желчного пузыря
Они нередко сочетаются с камнями в желчном пузыре или воспалением. Только 9% обследованных имели здоровый желчный пузырь (данные исследований). Эти полипы относятся к предопухолевым заболеваниям желчного пузыря.
Чтобы уточнить характер полипа - холестериновый или истинный полип, проводят ультразвуковое доплеровское исследование полипа, определяя наличие кровоснабжениев ножке полипа: при холестериновом полипе оно отсутствует, при истинном полипе кровоснабжение присутствует. При обнаружении истинного полипа желчного пузыря показано ежегодное ультразвуковое исследование.
Злокачественные полипы желчного пузыря
Их, по данным операции холецистэктомии, имели лица старше 60 лет.
Рак желчного пузыря является редким заболеванием, и встречается 1-2 случая на 100 000 человек.
Полипы размером более 1,5-2 см в просвете желчного пузыря и быстрый рост их более 2 мм в год входят в группу риска и требуют динамического наблюдения. Чаще злокачественные полипы желчного пузыря диагностируются в неоперабельной форме.
Диагностика полипов желчного пузыря
Исследование липидного (холестеринового) обмена
Холестерин входит в состав желчи, который вырабатывается печенью. Часть его выделяется вместе с желчью, но главным путем превращения холестерина является окисление его в печени до желчных кислот. Перенасыщение желчи холестерином возникает в случае повышенной секреции холестерина в желчь и при сниженной или недостаточной секреции желчных кислот.
Растворимость холестерина зависит от концентрации желчных кислот, которые образуют в растворе желчи холестериновые мицеллы. Снижение растворимости этих холестериновых мицелл играет большую роль в образовании полипов желчного пузыря.
Ультразвуковое исследование сократительной функции желчного пузыря
О проведении этого исследования можно прочесть в статье «Дискинезии желчевыводящих путей». В 70% полиповидные образования сочетались с различными вариантами нарушений сократительной функции желчного пузыря и желчевыводящих путей (дискинезий), деформациями желчного пузыря, чаще врожденного происхождения. В 30% являлись случайной находкой.
Это исследование исключает возможный застой желчи в желчном пузыре. При наличии его требует лечебной коррекции (режим питания, диетические особенности питания, гуманные тюбажи, лекарственные средства).
При обнаружении при УЗИ полипа или полипов встает вопрос о дифферециальной диагностике холестериновых полипов или холестероза и истинных полипов. Цветовое доплеровское ультразвуковое исследование позволяет отличить полипы от сгустков (хлопьев) желчи и различить холестериновые и истинные полипы: в холестериновых полипах отсутствует кровоток, в истинных полипах кровоток регистрируется.
Компьютерная томография
Она позволяет правильно поставить диагноз на дооперационной стадии болезни. Вопрос о необходимости операции решается индивидуально при наличии факторов риска опухолевого происхождения полипа.
Показания к холицистэктомии
Факторы риска, при которых показано оперативное лечение:
- возраст старше 60-70 лет,
- размеры полипа более 15-20 мм в диаметре,
- одиночный полип и наличие камней в желчном пузыре,
- отрицательная динамика при предшествующем УЗИ - рост полипа более чем на 2 мм за год,
- наличие полипа на тонкой ножке.
- наличие болевого синдрома.
Важна характеристика роста полипов:
- отсутствие роста, рост на 1 мм в год находится в пределах ошибки измерения,
- медленный рост — увеличение в диаметре более 2 мм в год,
- быстрый рост - более 2 мм в течение года, требует консультации хирурга, онколога.
Медикаментозное лечение
При отсутствии факторов риска и холестериновой природе образований желчного пузыря назначаются препараты желчных кислот - УДХК (урсодезоксихолиевой кислоты), которые являются методом лечения холестериновых полипов желчного пузыря под контролем УЗИ желчного пузыря. Длительность лечения, доза препарата, контроль эффективности лечения определяются врачом.
Действующим веществом УДХК является желчная кислота, которая образуется в организме человека. Прием препарата изменяет состав желчных кислот в желчи Это снижает всасывание холестерина в кишечнике и секреции холестерина в желчь. Следовательно, снижается насыщение желчи холестерином. УДХК обладает способностью образовывать с холестерином «жидкие кристаллы» и растворять холестериновый осадок. Всасывание УДХК происходит в проксимальных отделах тощей кишки и подвздошной.
Принимается препарат один раз в день во время ужина или на ночь. Это эффективно из-за соответствия суточному ритму образования и секреции холестерина, согласно которому содержание холестерина в желчи в течение ночи непрерывно возрастает, в течение дня падает. Считается, что холестериновые полипы растут преимущественно ночью.
УЗИ не всегда позволяет определить природу полипов и назначение УДХК является диагностическим тестом для разграничения холестериновых и истинных полипов.
УЗИ при ЖКБ. Трансабдоминальная сонография в диагностике предкаменной стадии желчно-каменной болезни
Желчно-каменная болезнь - длительный многостадийный процесс, при котором периоду камнеобразования предшествуют изменения метаболизма и физико-химических свойств желчи, нарушения тонуса и моторики билиарных путей и желчного пузыря. Холецистолитиаз - наиболее частая причина холецистоэктомий, которых в нашей стране выполняется около 600 тысяч в год. Желчно-каменная болезнь к 75 годам обнаруживается у 35% женщин и 20% мужчин. Внедрение малоинвазивных хирургических технологий привело к тому, что холецистэктомия стала основным методом лечения желчно-каменной болезни. В послеоперационном периоде в 5-20% случаев развивается постхолецистоэктомический синдром.
Проблема первичной профилактики холелитиаза, своевременной диагностики заболевания на предкаменной стадии и эффективности лечения имеют важное научно-практическое и социальное значение.
Первые попытки выделить предкаменную стадию ЖКБ были сделаны в 1974 году Small D., в 1982 году Мансуров Х.Х. предложил выделить начальную стадию ЖКБ, когда имеются лишь изменения физико-химических свойств желчи. В диагностике билиарной патологии основное место занимает трансабдоминальная ультрасонография (ТУС), позволяющая выявить макроскопически видимые изменения желчи, которые коррелируют с изменениями ее биохимического состава, и судить об эхооднородности желчи.
Предкаменная стадия ЖКБ
Предкаменная стадия ЖКБ подразделяется на стадию, при которой ультразвуковое исследование выявляет только неоднородную желчь и стадию сформировавшегося сладжа. С практической точки зрения наиболее важным является диагностика заболевания на стадии билиарного сладжа (клиническая классификация, разработанная НИИ гастроэнтерологии и рекомендованная III съездом НОГР). Основное клиническое значение билиарного сладжа заключается в том, что он является источником камнеобразования, дисфункции сфинктерного аппарата желчевыводящих путей и желчного пузыря, билиарный сладж - частая причина билиарного панкреатита. При длительной персистенции билиарного сладжа постоянный пассаж его в двенадцатиперстную кишку может осложниться развитием стриктуры терминального отдела общего желчного протока или стенозирующим папиллитом, редко острым холециститом, холангитом. По последним данным японских исследователей билиарный сладж является маркером раннего рака желчного пузыря.
Основные варианты билиарного сладжа:
- Эхонеоднородная желчь со сгустками: эхонеоднородная желчь с наличием единичных или множественных участков повышенной эхогенности, имеющих четкие или размытые контуры, смещаемых, без акустичесокой тени и, как правило, расположенных по задней стенке желчного пузыря;
- !Взвесь гиперэхогенных частиц (ВГЧ): точечные, единичные или множенственные, смещаемые гиперэхогенные образования, не дающие акустической картины, выявляемые при изменении положения тела пациента;
- Замазкообразная желчь: эхонеоднородная желчь с наличием участков, приближающихся по эхогенности к паренхиме печени, смещаемых или фиксированных к стенке желчного пузыря, с четким контуром, не дающим акустичекую тень, или в редких случаях с эффектом ослабления за сгустком.
В клинической практике в 70% встречается вариант билиарного сладжа - взвесь гиперэхогенных частиц (ВГЧ), частота обнаружения двух других вариантов сладжа составляет около 10-12%. Чувствительность трансабдоминальной сонографии в диагностике билиарного сладжа составляет 55-65%, а специфичность - более 90 %.
Состояние желчного пузыря
В патогенезе билиарного сладжа имеет значение состояние желчного пузыря и желчевыводящих путей:
- врожденные деформации желчного пузыря,
- функциональные заболевания желчевыводящей системы,
- органические заболевания желчевыводящей системы.
Дисфункция желчного пузыря
Дисфункция желчного пузыря - нарушение его моторики вследствие начальных метаболических нарушений (насыщение желчи холестерином) или первичных двигательных расстройств при отсутствии в начале аномалий состава желчи. Согласно Римских критериев III 2006 г., о дисфункции желчного пузыря говорят при наличии совокупности признаков: сохраненный желчный пузырь, отсутствие в нем камней, сладжа, микролитов и других органических изменений. Фракция выброса желчного пузыря составляет менее 40%.
При билиарном сладже часто наблюдается дискинезия желчного пузыря, которая может быть:
- первичной или вторичной (при органических заболеваниях желчевыводящих путей, язвенной болезни т.д.);
- гиперкинетической, нормокинетической или гипокинетической.
Билиарный сладж чаще сопровождается снижением сократительной функции желчного пузыря.
Для изучения сократительной функции желчного пузыря (холецистокинетический тест) проводится трансабдоминальная сонография с пробным завтраком. В качестве стандартного желчегонного завтрака возможно использовать: желтки 2 сырых яиц или сметану 15% жирности 100 г, или 200 мл 10% сливок, сорбит 30 г на 100 мл воды. Изучается базальный объем желчного пузыря и объем желчного пузыря после желчегонного завтрака через 30 минут. При сохраненной сократительной функции желчного пузыря коэффициент опорожнения составляет не менее 50% -70% через 30 минут после желчегонного завтрака.
Исследование сфинктера Одди
Несмотря на то, что УЗИ позволяет достаточно точно судить о функциональном состоянии желчного пузыря, диагностика дисфункции сфинктера Одди с помощью УЗИ затруднена.
Дисфункция сфинктера Одди — нарушение его моторики, проявляющееся клиническим симптомокомплексом, уклонением печеночных и панкреатических ферментов, дилятацией холедоха или эпизодами панкреатита. Подтверждается дисфункция сфинктера Одди, (согласно Римским критериям III, 2006 г.) данными УЗИ-исследования (холедох > 8 мм, увеличение его просвета после стимуляции), магнито-резонансной холангиопанкреатографии, холесцинтиграфия, ЭРХПГ (холедох > 12 мм, базальное давление > 40 мм рт. ст.).
При билиарном сладже и при гипокинезии желчного пузыря наблюдается гипертонус сфинктера Одди.
При метеоризме, выраженной избыточной массе тела исследование УЗИ затруднено, в этих ситуациях необходимо дополнить УЗИ эндоскопической ультрасонографией, информативность которой в диагностике билиарного сладжа существенно выше (чувствительность 92-96 %, специфичность — 86-100 %). Также эндоскопическая ультрасонография показана в тех случаях, когда имеются трудности в проведении дифференциальной диагностики между фиксированным к стенке желчного пузыря сгустком замазкообразной желчи и пристеночным образованием, в первую очередь опухолевого генеза.
Исследование состояния стенки желчного пузыря
ТУС позволяет изучить состояние стенки желчного пузыря и провести дифференциальную диагностику наличия холестероза желчного пузыря, воспаления или мелких камней, не дающих «акустическую тень», путем изменения мощности режима работы аппарата.
Холестероз желчного пузыря - заболевание, обусловленное накоплением в стенке желчного пузыря липидов (свободного холестерина, триглицеридов, свободных жирных кислот) из желчи, сопровождающееся нарушением его функции.
Классификация холестероза на основе макроскопических форм поражения слизистой оболочки желчного пузыря: очаговая сетчатая, диффузно-сетчатая, полипозная, смешанная сетчато-полипозная.
Эхографические диагностические критерии холестероза желчного пузыря
Сетчатая форма холестероза характеризуется наличием внутренней зернистой выстилки, визуализация которой улучшается при снижении мощности УЗ сигнала, межреберном сканировании, при сокращении желчного пузыря. Прогрессирование процесса, поражение подслизистого и мышечного слоев, сопровождается неравномерным повышением эхогенности стенки при ее утолщении не более 1-2 мм.
Полиповидная форма холестероза
Эхографическая картина холестеринового полипа представлена несмещаемыми пристеночными образования повышенной эхогенности с зернистым контуром и структурой, размеры до 10 мм. Холестериновый полип имеет причудливую форму, часть их располагается на ножках, васкуляризация холестеринового полипа не определяется, но визуализируется при доплеровском исследовании, что необходимо для дифференциальной диагностики «чистого» холестеринового полипа и железистого полипа.
По данным УЗИ, холестероз встречается в 40 % случаев больных с билиарной патологией, наиболее часто в возрасте 40-59 лет, локализуется в теле желчного пузыря, в 62 % случаев сочетается с билиарным сладжем, в 28 % — с холецистолитиазом, 40 % отмечается снижение сократительной функции желчного пузыря.
Воспалительные изменения стенки желчного пузыря
Она представляется более плотной и утолщенной - всегда более 3-3.5 мм.
В алгоритм ультразвукового исследования желчного пузыря входят:
- ТУС исследование;
- эндоскопическая ультрасонография,
- цветовое допплеровское исследование;
- сократительная функция желчного пузыря.
ТУС дает возможность динамического наблюдения за больным с билиарным сладжем и является объективным методом контроля за эффективностью лечения.
Заключение протокола УЗИ
- Форма, размеры и объем желчного пузыря.
- Оценка качества желчи в соответствии с «классификацией сладжа», предполагаемый объем сладжа натощак и после пробного завтрака.
- Размеры общего желчного протока, дисфункция сфинктера Одди (критерии?)
- Характеристика сократительной функции желчного пузыря:
- количественный тест-показатель Vо — первоначальный объем желчного пузыря натощак,
- пробный завтрак: сорбит 30 мл на 100 мл воды,
- тест-показатель времени оценки сокращения желчного пузыря - 30 минут после пробного завтрака,
- тест-показатель объема желчного пузыря через 30 минут после пробного завтрака — V1,
- процент сокращения желчного пузыря % (N-50-70%) (функциональная дисфункция желчного пузыря).
Вас может заинтересовать:
![Кислотозависимые заболевания]()
![Дисбиоз кишечника]()
![Метаболический синдром]()
Дифференциально диагностическая оценка состояния печени у больных хроническим панкреатитом и при сочетании его с метаболическим синдромом
Ультразвуковая диагностика холестероза желчного пузыря
![]()
Идеальный инструмент для пренатальных исследований. Уникальное качество изображения и весь спектр диагностических программ для экспертной оценки здоровья женщины.
Введение
Ультрасонография является одним из самых информативных и доступных инструментальных методов диагностики заболеваний желчного пузыря. Акустические свойства ультразвука позволяют выявлять мельчайшие эхогенные структуры, выступающие из стенки желчного пузыря в его просвет [1,2,3].
Ультразвуковое заключение "полипы" или "полипоз желчного пузыря " - собирательное понятие, которое объединяет разнообразные гистологические формы доброкачественных опухолей и опухолеподобных изменений этого органа. Эхографические характеристики неспецифичны для различных морфологических вариантов новообразований желчного пузыря. Благодаря широкому внедрению ультразвуковой диагностики частота эхографического обнаружения полипов желчного пузыря, которые раньше считались относительно редким заболеванием и были случайными находками при холецистэктомиях, составляет в настоящее время при массовых скрининговых исследованиях 3-5,6 % [6]. Наиболее частой гистологической формой его полиповидных структур является холестероз. Другие морфологические варианты включают гиперпластические, фиброзные полипы, аденомиоматоз, аденому, гетеротопию слизистой, аномалии эпителия. К злокачественным новообразованиям желчного пузыря относят аденокарциному (наиболее часто), карциносаркому, карциноид, метастатическое поражение. Они составляют около 1 % всех полиповидных образований этого органа [11].
Материал и методы
Нами проведен сравнительный анализ результатов ультразвукового, операционного и морфологического исследований, направленных на холецистэктомию с клиническим диагнозом "полипы" или "полипоз желчного пузыря" у 98 пациентов. После операции были получены следующие заключения патоморфологического исследования удаленного желчного пузыря: холестероз желчного пузыря (диффузная и диффузно-полиповидная формы) - 42 % (41 пациент), аденома - 11,5 %, аномалии эпителия (гипертрофия или гиперплазия слизистой на фоне хронического холецистита) - 9 %, аденомиоматозная гиперплазия - 5 %, полипы (фиброзные и гиперпластические) - 26,5 %. В 6 % случаев диагноз при направлении на операцию оказался ложноположителъным. Были обнаружены мелкие конкременты, фиксированные к стенке желчного пузыря (4 %), либо деформации стенки желчного пузыря в результате перихолецистита (2 %). Ни в одном из 98 случаев не было выявлено гистологических признаков злокачественного роста.
В задачу настоящей публикации входит анализ результатов обследования группы пациентов (41 человек), у которых имел место холестероз желчного пузыря. Среди них было 23 женщины и 18 мужчин в возрасте от 31 до 70 лет (средний возраст - 49,6 года). Ультразвуковое исследование органов брюшной полости было выполнено по общепринятой методике с использованием стандартной аппаратуры. Часть ультрасонографий выполнена на УЗ-сканере Medison SonoAce-9900. При анализе результатов были оценены следующие акустические признаки полипов желчного пузыря: количество, размеры, форма, эхогенность, наличие или отсутствие акустической тени, структура, контуры, характер ножки. В 10 случаях дополнительно проводилось цветовое допплеровское картирование.
Результаты исследования
Эхографические размеры полипов желчного пузыря оказались: 2-5 мм у 49 % пациентов, 6-10 мм - у 41 %, 11-22 мм - у 10 %. В 82 % случаев форма полипов была округлая. Эхогенность полипов в 70 % случаев определена как средняя, в 7 % - как низкая и в 23 % - как высокая. По сонографическим характеристикам полипы обычно соответствовали акустической плотности печени. Образования малых размеров (2-5 мм), как правило, были значительно более эхогенными по сравнению с крупными (16-22 мм).
Полиповидные образования имели однородную структуру (100 %) и в 98 % случаев не давали акустической тени. Ровный контур был у холестериновых полипов небольших размеров и выявлен в 80 % случаев, неровный отмечен у 10 % пациентов. Полипы размерами более 11 мм имели бугристую поверхность, которая обуславливала фестончатый контур при ультразвуковом исследовании.
Узкая ножка визуализировалась у 85 % пациентов, широкое основание - у 15 %. Иногда можно было выявить эхографический симптом "пламени свечи", при этом наблюдалось дрожание полипа. Такой феномен имел место при наличии полипов небольших размеров и вытянутой формы и свидетельствовал об их тонкой ножке. Холестерозные полиповидные выросты размерами 2-4 мм исходили как бы непосредственно из-под слизистого слоя и имели широкое основание. В нашей выборке все холестериновые полипы больших размеров (16-22 мм) имели тонкие ножки, хотя в части случаев эхографически создавалось впечатление о наличии широкого основания (рис. 1).
а) Полип размером 22 мм, с фестончатыми контурами, пониженной эхогенности, ложноположительная диагностика широкого основания из-за ограниченной смещаемости в просвете желчного пузыря.
![Макропрепарат, рыхлое строение, фрагментировался при отмывании желчи]()
б) Макропрепарат, рыхлое строение, фрагментировался при отмывании желчи.
![Микропрепарат, в структуре пенистые клетки, накопившие кристаллы холестерина, эфиры и желчные кислоты путем фагоцитоза, окраска гематоксилином и эозином]()
в) Микропрепарат, в структуре пенистые клетки, накопившие кристаллы холестерина, эфиры и желчные кислоты путем фагоцитоза, окраска гематоксилином и эозином.
Холестерозу чаще соответствовали множественные (3 и более) полипы желчного пузыря, которые встречались, по нашим данным, в 78 % случаев, 5 % - 2 полипа, одиночный - у 17 % пациентов.
При использовании в 10 случаях допплеровских методов ни внутри полипа, ни в его ножке кровоток зарегистрировать не удалось (рис. 2). Дрожание полипов в виде пламени свечи, свидетельствующее об их тонкой ножке, вызывает движение расположенных рядом с полипом слоев желчи. В результате этого около полипа регистрируется цветовой сигнал.
![УЗИ. Холестериновый полип размером 22 мм, в режиме цветного допплеровского картирования кровоток не регистрируется]()
Рис. 2. Холестериновый полип размером 22 мм, в режиме цветного допплеровского картирования кровоток не регистрируется.
При непосредственном исследовании макропрепарата желчного пузыря после холецистэктомии обычно хорошо различались признаки холестероза (рис. 3) в виде желтой сеточки и полиповидных выростов, исходящих непосредственно из подслизистого слоя, а также полиповидных образований на тонкой ножке, окрашенных в желтый цвет. Полипы размерами более 11 мм по внешнему виду напоминали ягоду ежевики, имели рыхлое строение и при отмывании желчи могли фрагментироваться. При морфологическом исследовании была выявлена полиповидная и диффузно-полиповидная (полиповидно-сетчатая) формы холестероза желчного пузыря.
Лучевая диагностика патологии желчного пузыря и желчевыводящих путей
![]()
Точная и уверенная диагностика. Многофункциональная ультразвуковая система для проведения исследований с экспертной диагностической точностью.
Заболевания желчного пузыря - это особый раздел в современной медицине, которому специалисты уделяют повышенное внимание 5. С одной стороны, патология желчного пузыря (например, полипы), может протекать совершенно бессимптомно, но имеет тенденцию к малигнизации 6. С другой стороны, некоторые заболевания, такие как конкременты желчного пузыря и желчевыводящих путей, сопровождаются сильными приступами болей и могут привести к тяжелым осложнениям. В результате длительного давления камнем на слизистую оболочку пузыря в ней могут возникнуть язвы и пролежни, образоваться дивертикулоподобные выпячивания, внутренние и наружные желчные свищи, перфоративные отверстия с развитием подпеченочного или поддиафрагмального абсцессов, желчного перитонита. Перемещение желчных камней может сопровождаться закупоркой пузырного протока, водянкой желчного пузыря или его эмпиемой. При обтурации камнем выходного отдела общего желчного протока наступает механическая желтуха. Длительное нахождение камня в желчных протоках и присоединение инфекции ведут к развитию холангита. Выпадение крупного желчного камня из желчного пузыря в кишку через образовавшееся соустье может привести к непроходимости кишечника [1, 3, 5-8, 10-12]. Поэтому своевременная диагностика заболеваний желчного пузыря и протоковой системы имеет очень важное значение.
Образование желчи в печени - процесс непрерывный, однако поступление ее в кишечник в норме происходит преимущественно в процессе пищеварения. Это обеспечивается резервуарной функцией желчного пузыря и его ритмическими сокращениями с последовательным расслаблением сфинктера Люткенса и далее сфинктера Одди, расположенного в месте впадения общего желчного протока в кишку (рис. 1).
![Схематическое изображение положения желчного пузыря на висцеральной поверхности печени: 1 - дно желчного пузыря; 2 - пузырный проток; 3 - собственная печеночная артерия; 4 - воротная вена; 5 - желудочно-печеночная связка; 6 - левая доля печени; 7 - хвостатая доля печени; 8 - нижняя полая вена; 9 - хвостатый отросток; 10 - шейка желчного пузыря; 11 - правая доля печени; 12 - тело желчного пузыря; 13 - квадратная доля печени]()
1 - дно желчного пузыря;
2 - пузырный проток;
3 - собственная печеночная артерия;
4 - воротная вена;
5 - желудочно-печеночная связка;
6 - левая доля печени;
7 - хвостатая доля печени;
8 - нижняя полая вена;
9 - хвостатый отросток;
10 - шейка желчного пузыря;
11 - правая доля печени;
12 - тело желчного пузыря;
13 - квадратная доля печени.Натощак желчный пузырь содержит 30-80 мл желчи, но он может концентрировать печеночной желчи в 5-10 раз больше. При застое желчи в пузыре ее количество может увеличиваться. У женщин желчный пузырь в состоянии функционального покоя имеет несколько больший объем, чем у мужчин, но сокращается быстрее. С возрастом сократительная функция желчного пузыря снижается.
Ультрасонография является одним из самых информативных и доступных инструментальных методов диагностики заболеваний желчного пузыря 6.
Акустические свойства ультразвука позволяют выявлять мельчайшие эхогенные структуры, находящиеся в желчном пузыре.
С помощью УЗИ значительно сокращается время диагностического поиска. В отличие от компьютерной томографии (КТ) и магнитно-резонансной томографии (МРТ) при УЗИ врач-исследователь сам непосредственно участвует в получении изображения, что имеет свои плюсы и минусы. Положительной является возможность более целенаправленного и детального исследования изучаемого объекта. Отрицательная сторона - качество изображения и его расшифровка в значительной степени зависят от опыта исследователя и правильности применяемых им методик.
Полипы в желчном пузыре имеются у 6% всего населения. В 80% случаев полипы в желчном пузыре отмечаются у рожавших женщин в возрасте после 30 лет. Так как полипы клинически себя никак не проявляют, диагностика их чаще всего случайна и происходит при проведении УЗИ у пациента по совершенно другим причинам 7.
Хотя причины появления полипов на стенках в желчного пузыря не установлены, а симптомы неочевидны, известны четыре типа таких образований. Наиболее часто по статистике в желчном пузыре у пациентов сегодня встречаются следующие типы [4, 5, 9].
Воспалительный полип желчного пузыря - является своего рода воспалительной реакцией самой слизистой оболочки желчного пузыря, проявляется у пациента в виде различных разрастаний грануляционной внутренней ткани пораженного органа.
Нередко врачи также ставят диагноз аденомы желчного пузыря. Так происходит потому, что это своего рода доброкачественная опухоль в виде полиповидного разрастания железистой ткани желчного пузыря больного.
Также следует отметить папиллому или полипоз желчного пузыря у некоторых пациентов. Такая папиллома представляет собой доброкачественную опухоль слизистой оболочки пузыря в виде различных по виду и структуре своеобразных папиллом или сосочковых разрастаний.
К самому распространенному типу относят так называемый холестериновый полип желчного пузыря, который представляет собой возвышение слизистой оболочки пузыря с холестриновыми отложениями на ней. Холестероз достаточно часто встречается среди пациентов, направленных на операцию с клиническим диагнозом "полипы" или "полипоз желчного пузыря", по некоторым данным от 42 до 95% случаев.
Ультрасонография является эффективным средством выявления полиповидной формы холестероза 9. Традиционной считается следующая сонографическая характеристика холестериновых полипов: неподвижные гиперэхогенные структуры, которые не дают акустической тени и прикрепляются к стенке желчного пузыря. Контуры таких образований, как правило, ровные, а размеры таких образований различны, чаще не превышают 10 мм (рис. 2).
![Эхограмма - одиночный полип в желчном пузыре (2а)]()
a) Одиночный полип в желчном пузыре (гиперэхогенное пристеночное неподвижное образование, с ровными контурами, без акустической тени).
![Эхограмма - одиночный полип в желчном пузыре (2б)]()
б) Одиночный полип в желчном пузыре.
![УЗ-картина полипов в желчном пузыре - полиповидно-сетчатая форма холестероза (2в)]()
в) Полиповидно-сетчатая форма холестероза, полипы размерами до 5 мм, повышенной эхогенности.
![Эхограмма - одиночный полип в желчном пузыре (2г)]()
г) Одиночный полип в желчном пузыре.
Однако, по некоторым данным, размеры холестериновых полипов могут быть более 20 мм. Кроме того, полипы больших размеров (в 7% от общего числа) могут иметь пониженную эхогенность и фестончатый контур.
Мелкие холестериновые включения, образующие диффузную сеточку в толще подслизистого слоя размерами 1-2 мм, выглядят как локальное утолщение или уплотнение стенки желчного пузыря и в некоторых случаях (см. рис. 2) вызывают реверберацию (эхографический симптом "хвост кометы").
При распространенном холестерозе визуализируются множественные гиперэхогенные образования, дающие картину "земляничного" желчного пузыря (рис. 3).
![Эхограмма - множественные полипы в желчном пузыре, картина земляничного желчного пузыря]()
а) Множественные полипы в желчном пузыре, картина "земляничного" желчного пузыря.
![УЗ-картина полипов в желчном пузыре - режим ЦДК, кровоток не регистрируется]()
б) В режиме цветного допплеровского картирования кровоток не регистрируется.
Характер ножки полипа традиционно учитывается в онкологической практике как признак, ассоциированный со злокачественной природой образования. Вероятность возможной малигнизации больше, если у него имеется широкое основание, а не тонкая ножка. Однако необходимо принимать во внимание возможность ложноположительной диагностики широкого основания при полипах больших размеров из-за их ограниченной смещаемости в просвете желчного пузыря. Дрожание, напоминающее пламя свечи, наблюдается у полипов небольших размеров и вытянутой формы, и указывает на их тонкую ножку 9.
Желчнокаменная болезнь (cholelithiasis; калькулезный холецистит) - заболевание, обусловленное наличием конкрементов в желчном пузыре и желчных протоках. Частота образования желчных камней увеличивается с возрастом, достигая 45-50% у женщин старше 80 лет. У мужчин желчные камни встречаются в 3-5 раз реже, у детей - крайне редко. Только в 20% случаев желчные камни существуют бессимптомно ("немые" конкременты) [5].
Существует два основных механизма образования желчных камней: печеночнообменный и пузырно-воспалительный. Печеночно-обменный механизм заключается в формировании желчных камней вследствие таких факторов, как несбалансированное питание с преобладанием в рацио не грубодисперсных животных жиров (свиного, бараньего, говяжьего) в ущерб растительным; нейроэндокринные нарушения, например, связанные с дисфункцией эндокринной системы возрастного характера и гипофункцией щитовидной железы; поражения печеночной паренхимы токсического и инфекционного генеза; гиподинамия и застой желчи. В результате печень продуцирует литогенную желчь, т. е. способную образовывать холестериновые или смешанные камни. При пузырно-воспалительном механизме желчные камни формируются под влиянием воспалительного процесса в желчном пузыре, приводящего к физико-химическим сдвигам в составе желчи (дисхолии). Изменение рН желчи в кислую сторону, характерное для любого воспаления, приводит к уменьшению защитных свойств коллоидов, в частности белковых фракций желчи, переходу мицеллы билирубина из взвешенного состояния в кристаллическое. При этом образуется первичный кристаллизационный центр с последующим наслоением других ингредиентов желчи, слизи, эпителия и др.
Желчные камни - плотные образования, количество которых может составлять от одного до нескольких тысяч, размер - до нескольких сантиметров в диаметре, масса - до 30 г и более. В желчном пузыре чаще встречаются камни округлой формы, в общем желчном протоке - эллипсоидной или продолговатой, во внутрипеченочных протоках ветвистой. В зависимости от состава различают холестериновые, пигментно-холестериновые, холестериново-пигментно-известковые, пигментные и известковые камни; на распиле они имеют пигментное ядро и слоистое строение.
Клиническая картина желчнокаменной болезни многообразна [5-6, 10]. Условно выделяют хроническую болевую, хроническую рецидивирующую, диспептическую, стенокардитическую и ряд других клинических форм. Характерным ультразвуковым признаком конкремента в желчном пузыре является его акустическая тень. Такая тень возникает из-за высокой плотности камня по сравнению с мягкими тканями. Наличие или отсутствие тени помогает отличить камень от полипа желчного пузыря (рис. 4).
![Эхограмма - одиночный конкремент желчного пузыря]()
а) Одиночный конкремент желчного пузыря (подвижная гиперэхогенная структура, дающая четкую теневую дорожку).
Читайте также: